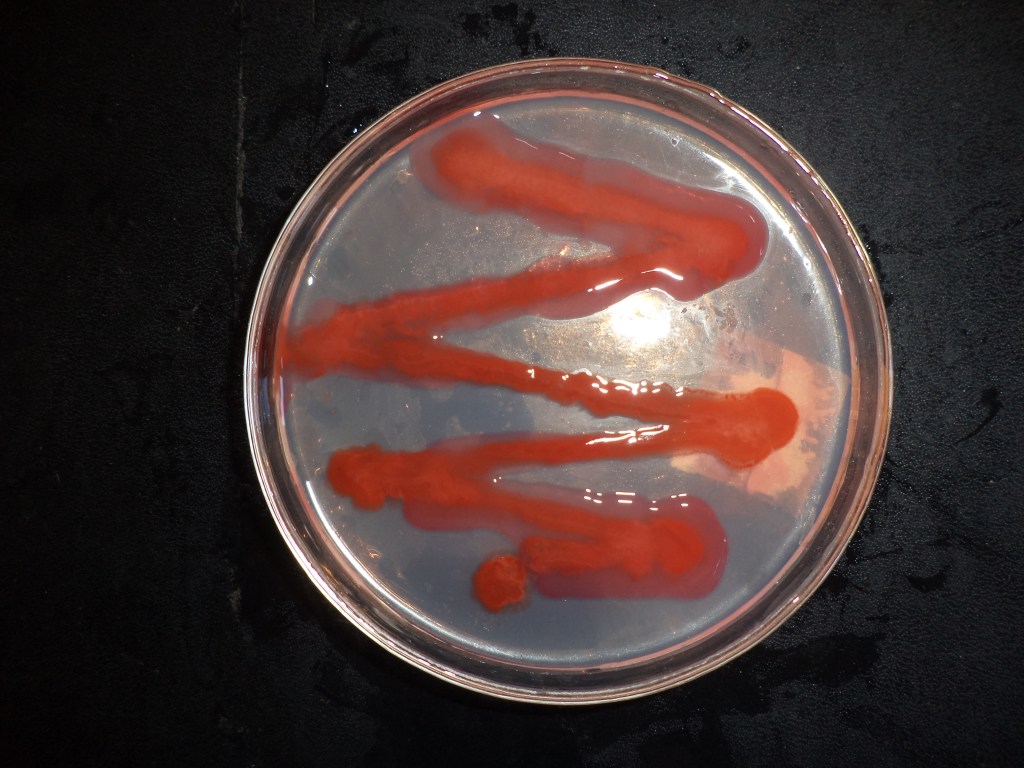
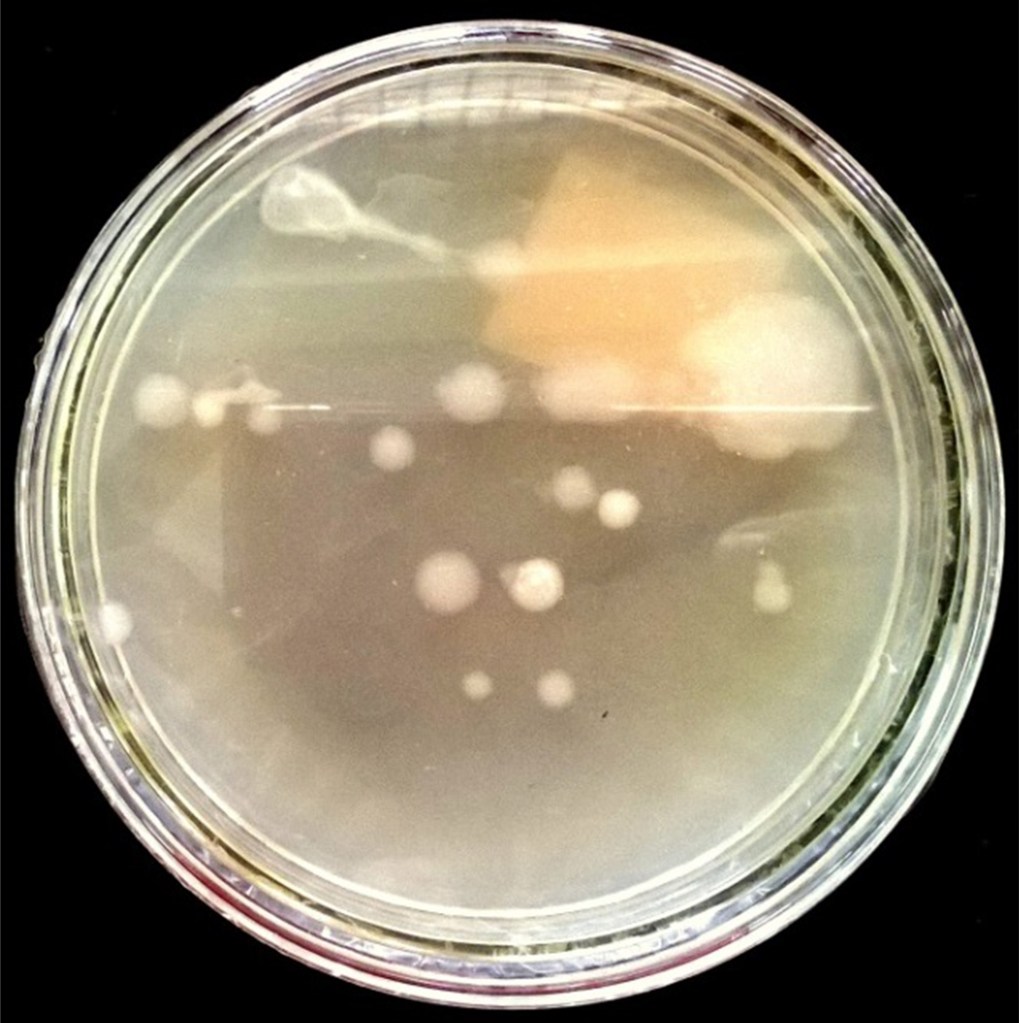

Curiosity driven life
This is the home page’s excerpt
Curiosity driven life
(Gunawardana Research Lab)
This is the home page’s excerpt
I am an independent researcher from Sri Lanka working on a myriad of topics
1. Azolla pinnata and cyanobionts
2. Rhizobial and Non-rhizobial nodulation in legumes
3. Wild rices and resident nitrogen fixers
4. Mitigation of nitrous oxide using biological solutions and other climate change themes
5. Bioinformatics solutions to biological questions
6. Plant and human nutrition
7. Science poetry
8. Teaching academic writing
This is my webpage……